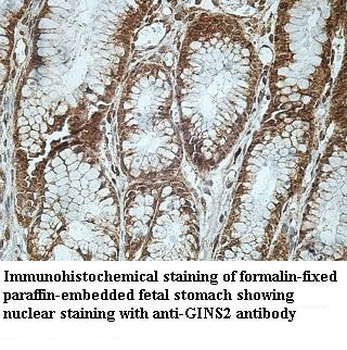
GINS2 Rabbit Polyclonal Antibody

You have no items in your shopping cart.
Cart summary

GINS2 Antibody
Catalog Number: orb794576
Product Properties
| Catalog Number | orb794576 |
|---|---|
| Category | Antibodies |
| Description | This GINS2 Antibody is an unconjugated polyclonal product. It tagets GINS2 using a a synthesized peptide derived from Escherichia coli O45:K1 (strain S88 / ExPEC) mutL as the immunogen. This antibody is suitable for ELISA, WB. Purification: Antigen Affinity. |
| Target | GINS2 |
| Clonality | Polyclonal |
| Species/Host | Rabbit |
| Isotype | IgG |
| Conjugation | Unconjugated |
| Reactivity | A. thaliana |
| Form/Appearance | Liquid |
| Buffer/Preservatives | Preservative: 0.03% Proclin 300. Constituents: 50% Glycerol |
| Purification | Antigen Affinity |
| Immunogen | A synthesized peptide derived from Escherichia coli O45:K1 (strain S88 / ExPEC) mutL. |
| UniProt ID | Q9C7A8 |
| Tested applications | ELISA, WB |
| Application notes | 1. Antibody purity > 90% confirmed by SDS-PAGE; 2. Antibody titer > 1: 64,000 confirmed by ELISA; 3. WB (positive for the antigen / recombinant immunogen protein). |
| Storage | Maintain refrigerated at 2-8°C for up to 2 weeks. For long term storage store at -20°C in small aliquots to prevent freeze-thaw cycles. |
| Alternative names | DNA replication complex GINS protein PSF2 GINS2 At Read more... |
| Note | For research use only |
Images
Similar Products
PSF2 Rabbit Polyclonal Antibody [orb100829]
IF, IHC-Fr, IHC-P
Canine, Human, Mouse, Porcine
Rat
Rabbit
Polyclonal
Unconjugated
100 μl, 200 μl, 50 μlGINS2 Rabbit Polyclonal Antibody [orb178266]
ELISA, IHC, WB
Mouse, Rat
Human
Rabbit
Polyclonal
Unconjugated
100 μg
Reviews
GINS2 Antibody (orb794576)
Based on 0 reviews
Participating in our Biorbyt product reviews program enables you to support fellow scientists by sharing your firsthand experience with our products.
Login to Submit a Review